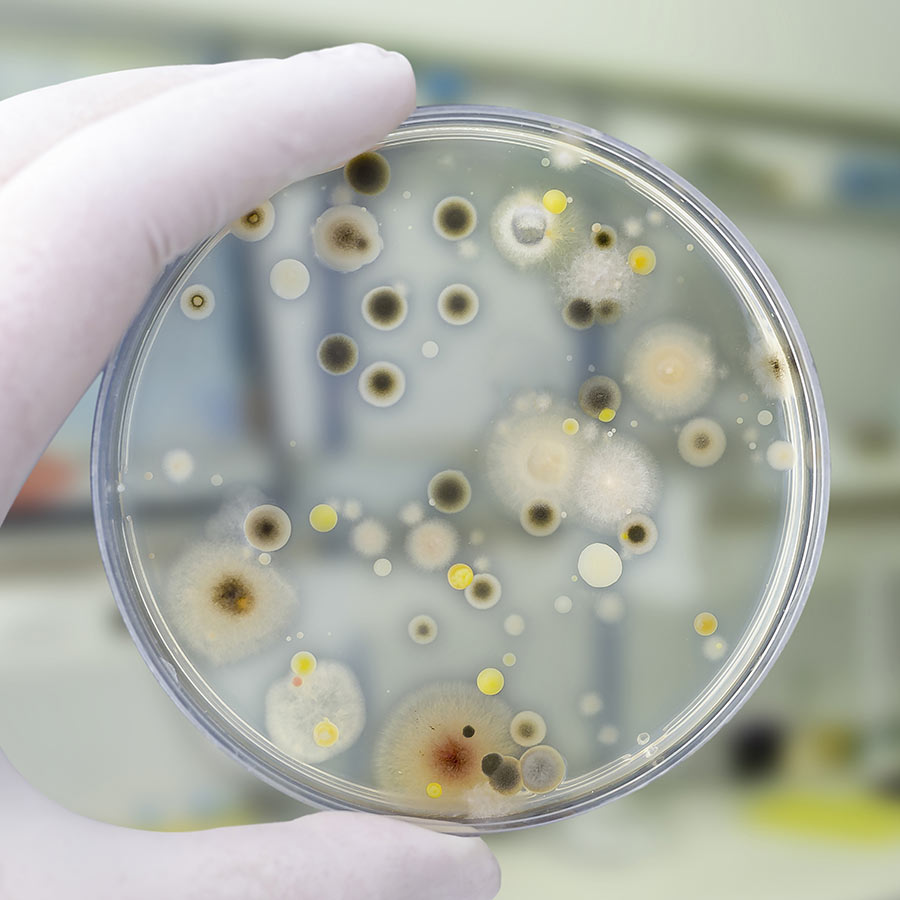

Settore Medicale
Produzione e progettazione camere bianche per settore ospedaliero-medicale
La camera bianca sterile è un ambiente irrinunciabile in specifiche aree produttive di molte tipologie di industria, inclusa quella farmaceutica e ospedaliera. L’obiettivo delle camere bianche sterili, ottenuto sempre attraverso un’appropriata progettazione e realizzazione degli ambienti, è quello di raggiungere ed ottenere condizioni ottimali non soltanto per il ciclo produttivo, ma anche per il benessere degli operatori al suo interno.
La camera bianca sterile è caratterizzata da un assoluto controllo della contaminazione, e la tipologia dei contaminanti da controllare, naturalmente, si differenzia a seconda del processo produttivo e dell’industria di riferimento. Pertanto, ogni progetto andrà valutato singolarmente, tenendo sempre conto dei suoi parametri, requisiti e specifiche esigenze.
Delta2000 è l’azienda di riferimento per il design, la produzione e l’allestimento di camere bianche sterili e dunque microbiologicamente controllate, destinate a qualunque settore produttivo, compreso quello farmaceutico e biomedicale.
Camere bianche per settore ospedaliero
Sale Operatorie
La camera bianca ospedale è normalmente utilizzata nell’industria biomedicale e deve assicurare specifiche caratteristiche tecniche, ma anche di sicurezza e affidabilità.
Anche conosciuta con il nome di “laboratorio pulito”, la camera bianca per ospedale è caratterizzata dall’assenza di microparticelle: è pertanto fondamentale che la sua progettazione e realizzazione avvenga da parte di un’azienda specializzata, caratterizzata da notevole know-how e grande esperienza nel settore biomedicale.
Delta2000 è oggi il partner d’eccellenza di numerose aziende ospedaliere e medicali alla ricerca della massima garanzia di qualità in termini di realizzazione di camere bianche per ospedali. A partire dal design, sino alla produzione e alla messa in opera, le nostre camere bianche sono il frutto di una tecnologia collaudata e di solide competenze.
Le camere bianche per ospedale devono necessariamente rispettare tutte le norme relative ai materiali per i settori farmaceutico e medicale, e sono suddivise in specifiche classi, a seconda del grado di purezza dell’aria di lavoro. In ogni caso, ogni cleanroom dovrà sempre garantire un ambiente a contaminazione controllata ed evitare l’inquinamento dell’aria da parte di microorganismi o particelle inquinanti, e pertanto sarà caratterizzata da massima pulizia e da un sistema di aerazione filtrante di altissima qualità.

Camere bianche per settore medicale
Laboratori
La camera bianca asettica è un ambiente che può essere adibito a laboratorio chimico e che è caratterizzato dall’assenza di aria contaminata, ossia da un bassissimo, quasi nulla contenuto di microparticelle di polvere in sospensione.
Conosciuta anche con il nome di cleanroom, si distingue per un’atmosfera controllata in termini di pressione atmosferica e di inquinamento particellare. Il suo funzionamento è basato sul principio di ricircolo forzato di aria super-filtrata, all’interno di un ambiente sigillato.
Nelle camere bianche asettiche, la purezza dell’aria può essere superiore a quella di una sala operatoria. Generalmente, gli operatori di una cleanroom asettica indossano camici sterili, copriscarpe, mascherine e cuffie e sono adeguatamente addestrati, così da non compromettere la purezza dell’aria.
Camere bianche per settore ospedaliero
Radiologia
Le cleanroom di radiologia devono rispettare i consueti requisiti di purezza e controllo dell’aria normalmente attribuibili alle camere bianche. Bisogna infatti tenere sempre in considerazione la grande delicatezza dei macchinari generalmente utilizzati in questi ambienti e l’importanza di non contaminarli in nessun modo, pena il pregiudicare il risultato delle loro operazioni.
Le particelle in sospensione nell’aria, conosciute anche con il nome di micropolveri, possono infatti danneggiare irreparabilmente i circuiti elettronici: la presenza di cleanroom in radiologia è ormai ampiamente documentata, soprattutto con finalità di miglioramento degli ambienti di produzione, di efficienza e di rendimento in termini di qualità dei risultati.

Camera sterile
Ambiente irrinunciabile per il settore ospedaliero
La camera sterile è da considerarsi uno spazio di primaria importanza per l’ambiente ospedaliero, e deve essere necessariamente il risultato di un’attenta consulenza preliminare, di un’accurata progettazione e design, e infine di un’adeguata realizzazione e gestione.
La camera sterile è utilizzata sia in ambito ospedaliero e farmaceutico che, in generale, in tutti quegli ambienti che richiedono una produzione protetta da fonti di inquinamento sia endogene che esogene, ossia interne o esterne. La massima cura del processo produttivo all’interno della camera sterile deve poter assicurare una gestione priva di sbavature per tutti i componenti trattati, così da dare vita a prodotti di alta qualità ed eccellenti dal punto di vista della performance.
Progettare e realizzare una camera sterile con la collaborazione di un’azienda altamente qualificata come Delta2000 significa potersi interfacciare con una realtà operante nel settore da oltre vent’anni, e in grado di garantire al proprio interlocutore una consulenza eccellente e una presa in carico completa dell’intero progetto. La camera sterile proposta da Delta2000 è una struttura solida e resistente, completamente indipendente e integrabile, capace di garantire gli standard di purezza richiesti sia nell’industria ospedaliera che in qualunque altro ambito professionale.
Entrate subito in contatto con gli esperti Delta2000 per progettare il vostro ambiente a contaminazione controllata: il nostro obiettivo è dare vita a una camera sterile, o più clean room, finalizzata alla minimizzazione dell’introduzione, della generazione e della ritenzione di particelle aerotrasportate, così da permettere la massima sicurezza nell’ambito di attività sensibili alla contaminazione.
Richiedete subito una consulenza per la progettazione della camera sterile più evoluta e performante.